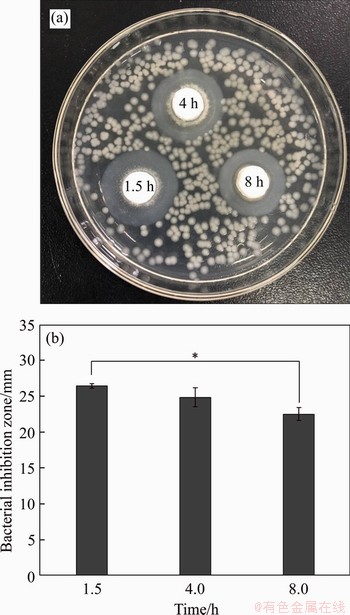

J. Cent. South Univ. (2020) 27: 3227-3238
DOI: https://doi.org/10.1007/s11771-020-4542-4

Preparation of tricalcium silicate and investigation of hydrated cement
TAN Yan-ni(̷����), CHEN Wen-juan(���ľ�), LIU Yong(��ӽ), LIU Yan-jun(���̾�)
State Key Laboratory of Powder Metallurgy, Central South University, Changsha 410083, China
 Central South University Press and Springer-Verlag GmbH Germany, part of Springer Nature 2020
Central South University Press and Springer-Verlag GmbH Germany, part of Springer Nature 2020
Abstract:
Tricalcium silicate cement (TSC) has been widely used in dental materials because of its self-setting behavior, good bioactivity, biocompatibility, osteoinductivity, and antibacterial effect. Tricalcium silicate (C3S) powder was prepared by Pechini technique with a calcining temperature of 1300 ��C for 3 h. The influence of liquid/powder (L/P) rate on the setting time and the mechanical property of TSC was studied. Characterization methods including XRD, FTIR, SEM-EDS, TEM, and ICP-AES were utilized to study the properties of C3S powder and its hydrated cement. The bioactivity and biocompatibility of the cement were investigated by soaking test and cell culture, respectively. The results show that the L/P rate plays an important role in the setting time and the compressive strength of TSC. The surface of TSC was covered by hydroxyapatite deposition during the immersion experiment and the cells attachment on the surface of TSC was well, which indicated that TSC has good bioactivity and biocompatibility. In addition, TSC has excellent antibacterial properties against Staphylococcus aureus. In conclusion, TSC is a promising candidate for root canal filling materials.
Key words:
tricalcium silicate powder; chemical synthesis; inorganic compounds; microstructure��
Cite this article as:
TAN Yan-ni, CHEN Wen-juan, LIU Yong, LIU Yan-jun. Preparation of tricalcium silicate and investigation of the hydrated cement [J]. Journal of Central South University, 2020, 27(11): 3227-3238.
DOI:https://dx.doi.org/https://doi.org/10.1007/s11771-020-4542-41 Introduction
In the past decades, calcium silicate cements (CSCs) have been widely studied as the endodontology materials due to their self-setting behavior within the moist environment with water, blood or other body fluids, which is a significant feature of dental cements for clinical application [1-5]. CSCs are materials with hydraulicity, which are composed by 50%-75% of Ca3SiO5 (C3S), about 15%-30% of Ca2SiO4 (C2S) and a small number of Ca3Al2O6 (5%-10%) and gypsum (3-6%), approximately [6]. Due to the adequate physical properties, induction ability of cell proliferation and differentiation, as along with excellent bioactivity [7], inorganic cements that are based on silicate are used as materials with great promise for root canal therapy [8-11]. Calcium silicate-based biomaterials have the ability to induce the mineralization of hydroxyapatite (HAp) when being soaked into simulated body fluid. Silicon ion derived from the cements has a significant effect on promoting osteoblastic cell growth, differentiation, and osteogenic gene expression [12]. C3S has been utilized for bone tissue repair by itself or with addition compositions [9]. Mineral trioxide aggregate (MTA) produced in the late 1990 s is the earliest goods [13]. The main constituent of MTA is C3S. BioRoot RCS (Septodont) is another commercially product based on TSC appearing in the market in February 2015. The hydraulic C3S-based dental biocement composes of C3S, povidone, ZnO powders, calcium chloride and polycarboxylate solution [14]. Another dental cement that contains synthetical tricalcium silicate is EndoSequence BC Root Repair Material (Brasseler, Savannah, USA), which exhibits enhanced handling properties because of the pre-mixed modality and injectability [15].
The conventional method to synthesize traiclacium silicate powder is the solid-state method that usually calcines SiO2 and CaO or CaCO3 mixtures at very high temperatures. For obtaining pure product powder, repeated calcinations are also required due to the low reaction kinetics. In another report, C3S powder was made using a two-step precipitation process with the calcining temperature of 1400 ��C for 8 h [16]. The obtained particle size of the powder is finer than that via the sol-gel route. The particle size plays a vital role in the hydration process and affects some important properties of the material [17]. It is found that the inorganic cements prepared from powders with smaller particles size set faster and have an improved compressive strength [18]. The comparative study of two powders synthesized by sol-gel route and solid-state reaction was carried out. The results showed that the sol-gel samples had improved setting time, higher hardness value and better antimicrobial activity [19]. SORRENTINO [20] reported the preparation of the pure C3S powder by Pechini process. However, the properties of tricalcium silicate bio-cement prepared by Pechini method have not been studied.
The Pechini process is a polymer precursors method to prepare pure ceramic powders with high purity [21]. The method is on the basis of the capacity of some alpha-hydroxycarboxyl acids like citric acid, to react with some metallic ions with the formation of polybasic acid chelate compounds [22]. Ceramic powders with high purity can be produced by this method using a lower calcination temperature compared with the traditional solid preparation. In our previous study, pure Ca2SiO4 powder prepared by Pechini method had a good performance [23]. In this work, Pechini technique was used for synthesis of tricalcium silicate powder, and the properties of the hydrated cement were studied in terms of the phase composition, microstructures, mechanical properties, bioactivity, biocompatibility and antibacterial effect.
2 Experimental
2.1 Synthesis of C3S powder
C3S powder was synthesized using Pechini method. The silicon source was colloidal SiO2(40 wt% suspension in water, Sigma-Aldrich); the calcium source was Ca(NO3)2��4H2O (Sinopharm Chemical, China). Two raw materials with a Ca to Si molar ratio of 3 were solubilized into pure water, respectively. Citric acid (CA, C6H8O7��H2O, Sinopharm Chemical, China) which was dissolved into distilled water in advance was mixed with the solution. The molar ratio of citric acid to total cationic amount was 1:1. The mixed solution was stirred till it became clear. Then ethylene glycol (EG, C2H6O, Xilong Chemical, China) was added into the mixture with EG-to-CA molar ratio of 2:1. The final mixture was heated up to 80-100 ��C with stirring to vaporize the extra water in a fuming cupboard until forming a foamy gel. This product was dried overnight within the drying cabinet (150 ��C). The xerogel was ground to powders and then calcined in a furnace at 1200, 1300 and 1400 ��C for 3 h by increasing 10 ��C/min. Finally, the product was ground to fine powder.
2.2 Preparation of tricalcium silicate cement
To prepare the cement, tricalcium silicate powders calcined at 1400 ��C were blended homogeneously with distilled water for the formation of cement slurry. For studying the influence of the liquid to powder ratio (L/P) on the performance of TSC, a series of L/P (0.6, 0.7, 0.8, 0.9, 1.0 mL/g) were adopted. The cement slurries were filled into a cylindrical silicone molds with a dimension of 6 mm��12 mm (height). The specimens were hydrated within a 37 ��C incubator of 100% humidity. The samples were taken out from the molds after 7 d, and the end of each specimen was ground to be flat. The universal testing machine (Instron 3369, USA) was used to test the compressive strength of TSC. Gillmore needles were used for testing the setting time in terms of the international standards (ASTMC266-89). The light needle used to test the initial setting time has diameter of 2.13 mm, mass of 113.4 g. For the heavy needle used to measure the final setting time, the diameter was 1.05 mm and the mass was 454 g. The setting time was the moment when the needle cannot make an indentation on the surface of the cement sample.
2.3 Characterization
The crystalline composition of tricalcium silicate powder, as well as TSC was investigated using X-ray diffraction analysis (XRD, D/ruax 2550 PC, Japan). The molecular structure was detected using Fourier transform infrared spectroscopy (FTIR, Nicolet Model Nexus 670, USA) with KBr pellets. A laser particles size analyzer was conducted for analysis of the size distributions of all powders. The microstructure was characterized with field emission scanning electron microscope (FESEM, NOVA NANOSEM 230, USA).
2.4 Bioactivity and cytotoxicity of tricalcium silicate cement
Bioactivity is defined as the capacity of biomaterials to form chemical bonding with the surrounding bone tissue. It is usually assessed by the ability of forming HAp on its surface when being soaked into the simulated body fluid (SBF). SBF solution was made in terms of the formulation and the procedure reported by KOKUBO et al [24]. The tricalcium silicate powder was soaked into SBF for 1, 3, 5, 7 and 14 d. The inductively coupled plasma- atomic emission spectrometry (ICP-AES, ICAP7000 SERIES, USA) FESEM and energy dispersive X-ray detector (EDX, Axios mAx, Netherlands), transmission electronic microscopy (TEM, JEOL JEM-2100F, Japan), and FTIR were utilized to characterize the HAp formation on the surface.
Cell culture is generally used to test the biocompatibility of biomaterials. Disc-like TSC specimens with 2 mm in thickness and a diameter of 10 mm have been used. The mouse osteoblasts (MT3C3) and Dulbecco��S mODIFIED eAGLE mEDIum (DMEM, Gibco) were utilized for cell culture. The cells were stored at condition of 5% CO2 and 37 ��C. The DMEM was substituted per 2-3 d to feed those cells. After culturing for 5 d, the morphologies of the cells were characterized using SEM. Prior to observation, those cells were fixed on the surface of the samples, then the cells were coated with platinum. The process of fixation was as follows: 1) chemical fixation: soaking the sample in 2.5% glutaraldehyde and 0.1 mol/L phosphate buffer; 2) dehydration: dehydrating twice with 50%, 70%, 90% and 100% alcohol for 15 min each, respectively; 3) critical point drying: using liquid CO2 to replace the ethyl alcohol and then heating to the critical point.
In vitro cytocompatibility of the TSC (L/P= 0.6) was evaluated according to ISO 10993-5 [25]. The extract solutions of TSC were obtained according to following procedure. The TSC was ground to powder before passing the 300-mesh sieve. The TSC powder with a concentration of 200 mg/mL in cell culture medium was stored in a carbon dioxide incubator at 37 ��C for 24 h. Subsequently, the mixed solution was centrifuged. Then the supernatant solution was gathered and filtered by a 0.2 ��m filter membrane. This prepared TSC extract was diluted to several concentrations (6.25, 25, 50 and 100 mg/mL). Then, MC3T3 cells (100 ��L) were added to a 96-well plate. The cell density was 1.5��104 well-1. After culturing for 1 d, DMEM was displaced with 100 ��L TSC extract with different concentrations. Then, the cell viability was assayed using CCK-8 assay kit following manufacture��s protocol after 1 d.
2.5 Antibacterial property
The antibacterial property of TSC was analyzed by inhibition zone experiments. The Gram-positive bacteria Staphylococcus aureus were used as the test bacteria. The lysogeny broth (LB) agar medium was sterilized in a sterilizing pot and poured into a 10 cm sterilized Petri dish to prepare a plate medium. The bacterial suspension dilutions (100 ��L, 106 mL-1) were evenly diffused on the surface of agar gel. TSC tablets (10 mm in diameter) prepared with different curing time (1.5, 4, 8 h) were put on the plate at intervals and cultured in a 37 ��C incubator for 12 h. The plate was taken out and then their photos were taken. The diameter of the inhibition ring was measured.
2.6 Statistic analysis
Some data were calculated using mean �� standard deviation. By one way analysis of variance, the significance level was 0.05. When p value is lower than 0.05 (*), it means that the data have significant difference.
3 Results and discussion
The crystalline phases of tricalcium silicate powders calcined at 1200, 1300 and 1400 ��C are illustrated in Figure 1. Calcium oxide, as a possible by-product, has been found in MTA and commercially available C3S [26]. The results show that the powder contained Ca3SiO5 (PDF-49-0442), Ca2SiO4 and CaO phases after being calcined at 1200 ��C, which indicates that the chemical reaction is not complete at this temperature. After being calcined at 1300 ��C, the powder consists of mainly Ca3SiO5 with a small amount of CaO. After being calcined at 1400 ��C, the relative concentration of CaO is even lower than that of the powder calcined at 1300 ��C.

Figure 1 XRD results of C3S powders synthesized at 1200, 1300, 1400 ��C
Figures 2(a) and (b) present the FTIR patterns of dried gel before calcination and tricalcium silicate powder calcined at 1400 ��C, respectively. Figures 2(a) and (b) both show the broaden peaks at 3400 cm-1, which present the stretching bands of typical ��OH groups. The FTIR of dried gel (Figure 2(a)) presents the citrate ions (1440, 1627, and 2950 cm-1), functional group vibration bands (1730 and 1070 cm-1) of ester, and the absorption band of amorphous SiO2 (about 1110 and 800 cm-1). As shown in Figure 2(b), the bending and stretching vibration bands of the Si��O group (998, 894 and 520 cm-1) confirm the formation of calcium silicate [27].

Figure 2 FTIR spectra of dried gel before calcination (a) and tricalcium silicate powder calcined at 1400 ��C (b)
Figure 3 shows the particles size distribution of tricalcium silicate powder. The median- particle-size (D(v, 0.5)) is 35.41 ��m. The specific surface area is 826.7 m2/kg, which is larger than the tricalcium silicate powder prepared by the two-step precipitation method (397.78 m2/kg) in the literature [16]. It can be concluded from the above results that the Pechini method is a proper way to synthesize tricalcium silicate powder with high purity and high specific surface area. The key point to produce tricalcium silicate powder with high purity is mixing the Si and Ca source solution homogeneously. The organic materials used in this process are beneficial for the formation of a homogeneous and dispersed system. Hence, the ceramic powders produced by the Pechini method exhibit higher purity compared with sol-gel and solid-state method.

Figure 3 Particle size distribution of tricalcium silicate powder
Table 1 shows that the setting time of TSC increases with the increasing of liquid content. The initial setting time was 33 min when L/P ratio was 0.6 mL/g. It prolonged to 270 min when L/P ratio rose to 1.0 mL/g. It can be explained that the cement paste is more dilute and softer with more content of water, which leads to longer setting time. The setting speed of TSC is quite slow, especially when the L/P is 1.0 mL/g, the final setting time is more than 6 h.
Table 1 Setting time of calcium silicate cement with different L/P ratios

Figure 4 presents the influence of L/P on the compressive strength of TSC. The compressive strength will be improved if the L/P ratio reduces. When L/P is 1 mL/g, the cement shows the lowest strength (9.1 MPa); the cement possesses the highest compressive strength of 22.9 MPa when L/P=0.6 mL/g, which is close to commercially available C3S-based endodontic cements demonstrated in other work [28]. The reason may be that the increase of the liquid phase results in the increase of the porosity, which consequently causes the reducing of the compressive strength of TSC. The L/P ratio can affect the mechanical strength of cements through straightly changing their porosity [12]. The trend of the compressive strengths of TSC is consistent with that of the setting time [29].

Figure 4 Effect of L/P ratio on compressive strength of TSC
The XRD pattern of the hydrated tricalcium silicate cement is shown in Figure 5. It can be seen that a small amount of unreacted C3S peaks remained. It indicates that only a part of tricalcium silicate has experienced hydration reaction and non-crystalline calcium silicate hydrates (C-S-H gels) were formed. There are diffraction peaks that belong to Ca(OH)2 (Poretlandite, PDF-78-0315) in the pattern, which is similar to the report in the literature [30]. The tricalcium silicate powder can react with water through ��dissolved-precipitation�� reaction, resulting in forming C��S��H gels, along with calcium hydroxide [31]. The process of hydration reactions of tricalcium silicate is: 1) crystallographic tricalcium silicate is dissolved firstly; 2) C-S-H gel is formed; 3) crystallization of Ca(OH)2 occurs [32] as follows:
Ca3SiO5+3H2O��CaO-SiO2-H2O+2Ca(OH)2
The microscopic morphologies of the fractured sample after solidification of TSC are shown in Figure 6. There are macro pores in the cement structure which may be formed by the introducing of bubbles during the preparation process.Figures 6(b)-(d) show the microstructure of the cement. During the hydration process, C��S��H produced on the initial boundary of TSC particles is usually named as ��inner product��. Correspondingly, C��S��H formed by dissolving between particle interfaces is called ��outer product�� [33]. In Figure 6(b), the section marked with ��I�� is the relatively denser inner product C��S��H and the section marked with ��O�� is the needle-like outer product C��S��H. This is similar with the results shown in other literatures [34, 35]. The morphologies of needle-like C��S��H are shown in Figure 6(c), and Figure 6(d) shows the plate-like Ca(OH)2.

Figure 5 XRD pattern of TSC after being set for 7 d with L/P=0.6 mL/g
Figure 7 shows the morphologies of the initial tricalcium silicate powder and the tricalcium silicate powder after immersion into SBF for 3, 7, 14 d, as well as the EDX spectra of the surface deposition of tricalcium silicate powder after 14-d soaking. With the immersion time extending, the surface of tricalcium silicate powder is gradually covered with a layer of sediments and the layer becomes thicker. TEM (Figure 8) results show that the precipitation formed on the surface is nanoneedle-like after being soaked into SBF. EDX spectra (Figure 7(e)) of the soaked powder for 14 d reveals that the precipitation on the surface mainly consists of Ca, P and O, indicating the formation of calcium phosphate compounds. The existence of C peaks is caused by the application of carbon conductive adhesive. The XRD patterns (Figure 9) of the powder after immersion into SBF confirm the precipitation of HAp. The products were amorphous or poorly crystallized HAp (PDF-09- 0432). With the extension of time, the amorphous peaks become broader. Thus, the results indicate that tricalcium silicate has good bioactivity, which is beneficial for the bonding between the material and the tissues in vivo.

Figure 6 SEM images of TSC (a, b) (I: Inner product, O: outer product), fibrillar C-S-H (c), lamellar portlandite (d)
Table 2 shows the concentration change of Mg, Na, Si, P and Ca ions in SBF solution after 1-d soaking. The concentrations of K, Na and Mg ions remain steady after 1-d soaking, while the ion concentration of P, Si, and Ca changes significantly. The reason of the increase in Ca and Si ionic concentrations is the dissolution of TSC. The decrease of P ion concentration is caused by the formation of HAp, which consumes P ions.
Further, the ion concentration changes of Si, Ca, and P in SBF were measured after being soaked for 1, 3, 5, 7 and 14 d (Figure 10). The concentration curve of Ca2+ fluctuates during the immersion test. It is caused by the competition between the formation of HAp which consumes Ca ions and the dissolution of TSC which produces Ca ions. The concentration of P ions gradually decreases because of the HAp formation [36]. Si ion concentration is continually increasing due to the dissolution of TSC. Si is a crucial trace element in the preliminary stage of bone forming, and it is also vitally important on the mineralization of bone. Some researchers have reported that doping of Si into HAp is beneficial for the improvement of its bioactivity [37, 38]. A work that studied the influence of Si on the bioactivity of calcium phosphate [39] suggested that cells can react directly with the surface of the substrate containing Si, thus inducing the expression of osteoblastic phenotype. In addition, Si that releases from Si-rich substrate can promote the cell differentiation through a ��solution-mediated�� effect. Therefore, the release of Si from tricalcium silicate is also a key factor for its excellent bioactivity and biocompatibility.

Figure 7 SEM images of initial tricalcium silicate powder (a), tricalcium silicate powder after being soaked in SBF for 3 d (b), 7 d (c) and 14 d (d) and corresponding EDX (e)

Figure 8 TEM images of tricalcium silicate powder after immersion into SBF for 1 d (a), 3 d (b), 7 d (c) and 14 d (d)

Figure 9 XRD results of C3S powders after immersion into SBF for different time
Table 2 Ion concentrations of Ca, Na, P, Si, Mg after C3S was soaked into SBF for 1 d

Figure 11 shows the morphologies of MT3C3 cells cultured on the surface of TSC for 5 d. As shown in Figure 11(a), many cells were attached and grown on the surface with typical morphology of MC3T3 cells. It can be seen that the cells completely adhere on the surface and form polygon structures. Besides, lots of pseudopodia can be found in Figures 11(b)-(d). It indicates that TSC is promoting cell growth and is good in vitro biocompatibility.
The proliferation behavior of MC3T3 cells cultured with the TSC extracts for 1 d is presented in Figure 12. When the concentrations of TSC extract are below 50 mg/mL, MC3T3 cells have better viability than the blank control group. TSC has better cytocompatibility at lower extracts concentration. The decrease of the cell viability may be because of Ca(OH)2 released during the cement hydration, leading to an increase in pH of the surrounding medium [40]. Therefore, the pH of surrounding medium may increase if there is more TSC powder in the medium. Then it will lead to more cell death. TSC does not have any cytotoxicity and can induce MC3T3 cells growth.

Figure 10 Concentrations changes of Ca (a), P (b) and Si (c) during TSC being soaked into SBF

Figure 11 SEM images of MT3C3 cells after seeding on surface of TSC for 5 d

Figure 12 CCK-8 analysis of MC3T3 cells after being incubated with different concentrations of TSC powder extracts (The symbol �� * �� denotes that two groups are different significantly)
Figure 13 shows the antibacterial effect of TSC after curing at different time. The bacteriostatic ability of cement can be shown by the size of its peripheral transparent ring. After 12 h incubation, the inhibition zone of TSC after curing for 1.5 h ((24��0.36) mm) is the largest, followed by the inhibition zone ((21.0��1.27) mm) after curing for 4 h and the inhibition zone ((20.0��0.90) mm) after curing for 8 h is the smallest. It indicates that the antibacterial effect is the best when it is near the initial setting time and the antibacterial effect is weakened with the prolongation of curing time. Specifically, the bacterial inhibition ring of 1.5 h is the most significant among all the groups. The reason may be that lots of Ca2+ is released in the early stage of the curing reaction and lots of Ca(OH)2 is produced [41]. A large amount of Ca2+ is released immediately when TSC contacts with the aqueous solution. When the Ca2+ ions saturate in the aqueous solution, it gradually deposits on the surface of TSC granule for forming a hydrated C��S��H gel layer or Ca(OH)2, which makes the surrounding pH value increase to 11.0 and even higher [42]. The strong alkalinity inhibits the bacterial growth [43].
4 Conclusions
Pure tricalcium silicate powders were obtained by Pechini technique at a lower temperature (1300 ��C) for a shorter calcining time (3 h). The liquid-to-powder ratio shows a strong influence on the setting time and the compressive strength of TSC. With the reduction of L/P ratio, the setting time is shorter, and the compressive strength becomes higher. Amorphous C��S��H is formed after setting, as well as plate-like portlandite and needle-like C��S��H ��outer�� products. After being soaked into SBF, amorphous HAp is precipitated on the surface of TSC. Cells attach well on the surface of TSC. So, C3S powder prepared by Pechini method has excellent bioactivity and biocompatibility. TSC shows an excellent antibacterial effect. With the extension of curing time, the antibacterial effect decreases. In conclusion, Pechini method is a proper way for preparation of pure tricalcium silicate powder and the hydrated cement can be a promising candidate for repair of irregular bone defects.
Figure 13 Evaluation of antibacterial activity at different curing time (1.5, 4, 8 h) against Staphylococcus aureaus strain using agar diffusion assay
Contributors
TAN Yan-ni provided the concept and drafted the manuscript. CHEN Wen-juan did the most of the experiments. LIU Yong helped with the discussion and modified the manuscript. LIU Yan-jun helped with the cell culture and the antibacterial experiment.
Conflict of interest
The authors declare no conflict of interest.
References
[1] LIM J, GUK J G, SINGH B, HWANG Y C, SONG S J, KIM H S. Investigation on hydration process and biocompatibility of calcium silicate-based experimental portland cements [J]. Journal of the Korean Ceramic Society, 2019, 56(4): 403-411. DOI: 10.4191/kcers.2019.56.4.09.
[2] TORABINEJAD M, PARIROKH M, DUMMER P M H. Mineral trioxide aggregate and other bioactive endodontic cements: An updated overview-part II: Other clinical applications and complications [J]. International Endodontic Journal, 2018, 51(3): 284-317. DOI: 10.1111/iej.12843.
[3] PARIROKH M, TORABINEJAD M, DUMMER P M H. Mineral trioxide aggregate and other bioactive endodontic cements: An updated overview-part I: Vital pulp therapy [J]. International Endodontic Journal, 2018, 51(2): 177-205. DOI: 10.1111/iej.12841.
[4] HOSOYA N, TAKIGAWA T, HORIE T, MAEDA H, YAMAMOTO Y, MOMOI Y, YAMAMOTO K, OKIJI T. A review of the literature on the efficacy of mineral trioxide aggregate in conservative dentistry [J]. Dental Materials Journal, 2019, 38(5): 693-700. DOI: 10.4012/dmj.2018-193.
[5] MESCHI N, LI Xin, van GORP G, CAMILLERI J, van MEERBEEK B, LAMBRECHTS P. Bioactivity potential of Portland cement in regenerative endodontic procedures: From clinic to lab [J]. Dental Materials, 2019, 35(9): 1342-1350. DOI: doi.org/10.1016/j.dental.2019.07.004.
[6] TADDEI P, TINTI A, GANDOLFI M G, ROSSI P L, PRATI C. Ageing of calcium silicate cements for endodontic use in simulated body fluids: A micro-Raman study [J]. Journal of Raman Spectroscopy, 2009, 40(12): 1858-1866. DOI: 10.1002/jrs.2333.
[7] CAMILLERI J. Characterization and hydration kinetics of tricalcium silicate cement for use as a dental biomaterial [J]. Dental Materials, 2011, 27(8): 836-844. DOI: doi.org/ 10.1016/j.dental.2011.04.010.
[8] DAWOOD A E, PARASHOS P, WONG R H K, REYNOLDS E C, MANTON D J. Calcium silicate-based cements: Composition, properties, and clinical applications [J]. Journal of Investigative and Clinical Dentistry, 2017, 8(2): 1-15. DOI: 10.1111/jicd.12195.
[9] DUARTE M A H, MARCIANO M A, VIVAN R R, TANOMARU FILHO M, TANOMARU J M G, CAMILLERI J. Tricalcium silicate-based cements: Properties and modifications [J]. Brazilian Oral Research, 2018, 32(S1): 111-118. DOI: 10.1590/1807-3107bor-2018. vol32.0070.
[10] ABUSREWIL S M, MCLEAN W, SCOTT J A. The use of bioceramics as root-end filling materials in periradicular surgery: A literature review [J]. Saudi Dental Journal, 2018, 30(4): 273-282. DOI: 10.1016/j.sdentj.2018.07.004.
[11] JAFARI F, JAFARI S. Composition and physicochemical properties of calcium silicate based sealers: A review article [J]. Journal of Clinical and Experimental Dentistry, 2017, 9: 1249-1255. DOI: 10.4317/jced.54103.
[12] LIU Wen-juan, ZHAI Dong, HUAN Zhi-guang, WU Cheng- tie, CHANG Jiang. Novel tricalcium silicate/magnesium phosphate composite bone cement having high compressive strength, in vitro bioactivity and cytocompatibility [J]. Acta Biomaterialia, 2015, 21: 217-227. DOI: 10.1016/j.actbio. 2015.04.012.
[13] LEE S J, MONSEF M, TORABINEJAD M. Sealing ability of a mineral trioxide aggregate for repair of lateral root perforations [J]. Journal of Endodontics, 1993, 19(11): 541-544. DOI: doi.org/10.1016/S0099-2399(06)81282-3.
[14] SIBONI F A O, TADDEI P, ZAMPARINI F, PRATI C, GANDOLFI M G. Properties of BioRoot RCS, a tricalcium silicate endodontic sealer modified with povidone and polycarboxylate [J]. International Endodontic Journal, 2017, 50: 120-136. DOI: 10.1111/iej.12856.
[15] YAMAMOTO S, HAN L, NOIRI Y, OKIJI T. Evaluation of the Ca ion release, pH and surface apatite formation of a prototype tricalcium silicate cement [J]. International Endodontic Journal, 2017, 50: 73-82. DOI: 10.1111/ iej.12737.
[16] ZHAO Wen-yuan, CHANG Jiang. Two-step precipitation preparation and self-setting properties of tricalcium silicate [J]. Materials Science and Engineering C, 2008, 28(2): 289-293. DOI: doi.org/10.1016/j.msec.2007.01.007.
[17] ZHOU Yan-ling, XU Chen, WANG Xiao-ya, DOU Yuan-dong, HUAN Zhi-guang, CHANG Jiang. Fast setting tricalcium silicate/magnesium phosphate premixed cement for root canal filling [J]. Ceramics International, 2018, 44(3): 3015-3023. DOI: 10.1016/j.ceramint.2017.11.058.
[18] BELLMANN F, DAMIDOT D, MOSER B, SKIBSTED J. Improved evidence for the existence of an intermediate phase during hydration of tricalcium silicate [J]. Cement and Concrete Research, 2010, 40(6): 875-884. DOI: doi.org/ 10.1016/j.cemconres.2010.02.007.
[19] EL-HAMID H K, ABO-ALMAGED H H, RADWAN M M. Synthesis, characterization and antimicrobial activity of nano-crystalline tricalcium silicate bio-cement [J]. Journal of Applied Pharmaceutical Science, 2017, 7: 1-8. DOI: 10.7324/JAPS.2017.71001.
[20] SORRENTINO F. Upscaling the synthesis of tricalcium silicate and alite [J]. Cement Wapno Beton, 2008, 8: 177-183.
[21] FLORESGARAY K A, MART��NEZLU��VANOS A, CRUZORTIZ B R, GARC��ACERDA L A, LOPEZBADILLO C M. Synthesis of calcium silicates by Pechini method and exchanging ions of sodium alginate-calcium chloride [J]. Journal of the Spanish Ceramic and Glass Society, 2016, 55(6): 239-245. DOI: 10.1016/j.bsecv.2016.05.002. (in Spanish)
[22] GAKI A, PERRAKI T, KAKALI G. Wet chemical synthesis of monocalcium aluminate [J]. Journal of the European Ceramic Society, 2007, 27(2): 1785-1789. DOI: doi.org/ 10.1016/j.jeurceramsoc.2006.05.006.
[23] TAN Yan-ni, LIU Yong, ZHANG Qing, GURPREET B L. Synthesis of pure dicalcium silicate powder by the pechini method and characterization of hydrated cement [J]. Materials Science Forum, 2014, 787: 387-394. DOI: 10.4028/ www.scientific.net/MSF.787.387.
[24] KOKUBO T, TAKADAMA H. How useful is SBF in predicting in vivo bone bioactivity? [J]. Biomaterials, 2006, 27(15): 2907-2915. DOI: doi.org/10.1016/j.biomaterials. 2006.01.017.
[25] ISO/EN 10993-5. Biological evaluation of medical devices��Part 5. Tests for cytotoxicity, in vitro methods: 8.2 tests on extract [S].
[26] LIU W C, WANG H Y, CHEN L C, HUANG S W, WU C T, CHUNG R J. Hydroxyapatite/tricalcium silicate composites cement derived from novel two-step sol-gel process with good biocompatibility and applications as bone cement and potential coating materials [J]. Ceramics International, 2019, 45(5): 5668-5679. DOI: 10.1016/j.ceramint.2018.12.032.
[27] PRATI C, GANDOLFI M G. Calcium silicate bioactive cements: Biological perspectives and clinical applications [J]. Dental Materials, 2015, 31(4): 351-370. DOI: 10.1016/j.dental. 2015.01.004.
[28] GRECH L, MALLIA B, CAMILLERI J. Investigation of the physical properties of tricalcium silicate cement-based root-end filling materials [J]. Dent Mater, 2013, 29(2): e20-e28. DOI: 10.1016/j.dental.2012.11.007.
[29] LIU W C, HU C C, TSENG Y Y, SAKTHIVEL R, FAN K S, WANG A N, WANG Y M, CHUNG R J. Study on strontium doped tricalcium silicate synthesized through sol-gel process [J]. Materials Science and Engineering C, 2020, 108: 110431. DOI: doi.org/10.1016/j.msec.2019.110431.
[30] CAMILLERI J, SORRENTINO F, DAMIDOT D. Investigation of the hydration and bioactivity of radiopacified tricalcium silicate cement, biodentine and MTA Angelus [J]. Dental Materials, 2013, 29(5): 580-593. DOI: doi.org/10.1016/j.dental.2013.03.007.
[31] THOMAS J J. A new approach to modeling the nucleation and growth kinetics of tricalcium silicate hydration [J]. Journal of the American Ceramic Society, 2007, 90(10): 3282-3288. DOI: 10.1111/j.1551-2916.2007.01858.x.
[32] CUESTA A, ZEA-GARCIA J D, LONDONO-ZULUAGA D, de la TORRE A G, SANTACRUZ I, VALLCORBA O, DAPIAGGI M, SANF��LIX S G, ARANDA M A G. Multiscale understanding of tricalcium silicate hydration reactions [J]. Scientific Reports, 2018, 8(1): 8544-8565. DOI: 10.1038/s41598-018-26943-y.
[33] JUENGER M C G, MONTEIRO P J M, GARTNER E M, DENBEAUX G P. A soft X-ray microscope investigation into the effects of calcium chloride on tricalcium silicate hydration [J]. Cement and Concrete Research, 2005, 35(1): 19-25. DOI: doi.org/10.1016/j.cemconres.2004.05.016.
[34] FRANUS W, PANEK R, WDOWIN M. SEM Investigation of microstructures in hydration products of portland cement [C]// POLYCHRONIADIS E K, ORAL A Y, OZER M. 2nd International Multidisciplinary Microscopy and Microanalysis Congress. Springer International Publishing, 2015: 105-112.
[35] CALLEBAUT K, ELSEN J, van BALEN K, VIAENE W. Historical and scientific study of hydraulic mortars from the 19th century [C]// BARTOS P, GROOT C, HUGHES J. International RILEM Workshop on Historic Mortars: Characteristics and Tests. 2000: 125-133.
[36] HAO Feng-yu, QIN Li-mei, LIU Jing-dong, CHANG Jiang, HUAN Zhi-guang, WU Lin. Assessment of calcium sulfate hemihydrate�Ctricalcium silicate composite for bone healing in a rabbit femoral condyle model [J]. Materials Science and Engineering C, 2018, 88: 53-60. DOI: doi.org/10.1016/ j.msec.2018.02.024.
[37] SOUSA A, SOUZA K C, SOUSA E M B. Mesoporous silica/apatite nanocomposite: Special synthesis route to control local drug delivery [J]. Acta Biomaterialia, 2008, 4(3): 671-679. DOI: doi.org/10.1016/j.actbio.2007.11.003.
[38] ZHOU Xian-feng, ZHANG Nian-li, MANKOCI S, SAHAI N. Silicates in orthopedics and bone tissue engineering materials [J]. Journal Biomedical Materials Research A, 2017, 105(7): 2090-2102. DOI: 10.1002/jbm.a.36061.
[39] NING Cong-qing, MEHTA J, EL-GHANNAM A. Effects of silica on the bioactivity of calcium phosphate composites in vitro [J]. Journal of Materials Science: Materials in Medicine, 2005, 16(4): 355-360. DOI: 10.1007/s10856-005-0635-8.
[40] WU Meng, TAO Bai-long, WANG Tao, ZHANG Yue, WEI Wen-chao, WANG Chun-yu. Fast-setting and anti-washout tricalcium silicate/disodium hydrogen phosphate composite cement for dental application [J]. Ceramics International, 2019, 45(18): 24182-24192. DOI: 10.1016/j.ceramint. 2019.08.127.
[41] NATALE L C, RODRIGUES M C, XAVIER T A, SIMoES A, DE SOUZA D N, BRAGA R R. Ion release and mechanical properties of calcium silicate and calcium hydroxide materials used for pulp capping [J]. International Endodontic Journal, 2015, 48(1): 89-94. DOI: 10.1111/iej.12281.
[42] XU Chen, WEN Yang, ZHOU Yan-ling, ZHU Ya-qin, DOU Yuan-dong, HUAN Zhi-guang, CHANG Jiang. In vitro self-setting properties, bioactivity, and antibacterial ability of a silicate-based premixed bone cement [J]. International Journal of Applied Ceramic Technology, 2018, 15(2): 460-471. DOI: 10.1111/ijac.12813.
[43] RAN Shu-jun, LIU Bin, JIANG Wei, SUN Zhe, LIANG Jing-ping. Transcriptome analysis of enterococcus faecalis in response to alkaline stress [J]. Frontiers in Microbiology, 2015, 6: 1-11. DOI: 10.3389/fmicb.2015.00795.
(Edited by YANG Hua)
���ĵ���
�������Ʒ�ĩ����ˮ����Ʊ��������о�
ժҪ����������ˮ��(TSC)�����Թ̻������������ԡ�������ԡ����յ��ԺͿ����ԣ������Ʋ�����Ӧ�ù㷺�����IJ���Pechini����1300��C����3h�ɹ��ϳ��˹������Ʒ�ĩ���о���Һ�̱ȶ�TSC����ʱ���ǿ�ȵ�Ӱ�졣����XRD��FTIR��SEM-EDS��TEM��ICP-AES�ȱ����������о��˹������Ʒ�ĩ��ˮ����ˮ������ܡ�ˮ�������������Ժ����������Բ���ģ����Һ���ݺ�ϸ��ʵ������о������������Һ�̱Ȼ�����Ӱ��TSC�ij���������ʱ���ǿ�ȡ���ģ����Һ���ݺ�TSC���汻�ǻ���ʯ�����︲�ǡ�ϸ��ʵ�����ϸ������TSC����ܺõ�ճ������������˵��TSC���������������Ժ����������ԡ����⣬TSC�Խ��ɫ����������������������������á���֮��TSC�����㷺Ӧ���ڸ��ܳ�����ϡ�
�ؼ��ʣ��������Ʒ�ĩ����ѧ�ϳɣ���������۽ṹ
Foundation item: Project(2019JJ50797) supported by Hunan Provincial Natural Science Foundation of China
Received date: 2020-02-25; Accepted date: 2020-07-22
Corresponding author: TAN Yan-ni, PhD, Associate Professor; Tel: +86-731-88877669; E-mail: tanyanni@csu.edu.cn; ORCID: https://orcid.org/0000-0002-5453-5620
Abstract: Tricalcium silicate cement (TSC) has been widely used in dental materials because of its self-setting behavior, good bioactivity, biocompatibility, osteoinductivity, and antibacterial effect. Tricalcium silicate (C3S) powder was prepared by Pechini technique with a calcining temperature of 1300 ��C for 3 h. The influence of liquid/powder (L/P) rate on the setting time and the mechanical property of TSC was studied. Characterization methods including XRD, FTIR, SEM-EDS, TEM, and ICP-AES were utilized to study the properties of C3S powder and its hydrated cement. The bioactivity and biocompatibility of the cement were investigated by soaking test and cell culture, respectively. The results show that the L/P rate plays an important role in the setting time and the compressive strength of TSC. The surface of TSC was covered by hydroxyapatite deposition during the immersion experiment and the cells attachment on the surface of TSC was well, which indicated that TSC has good bioactivity and biocompatibility. In addition, TSC has excellent antibacterial properties against Staphylococcus aureus. In conclusion, TSC is a promising candidate for root canal filling materials.


